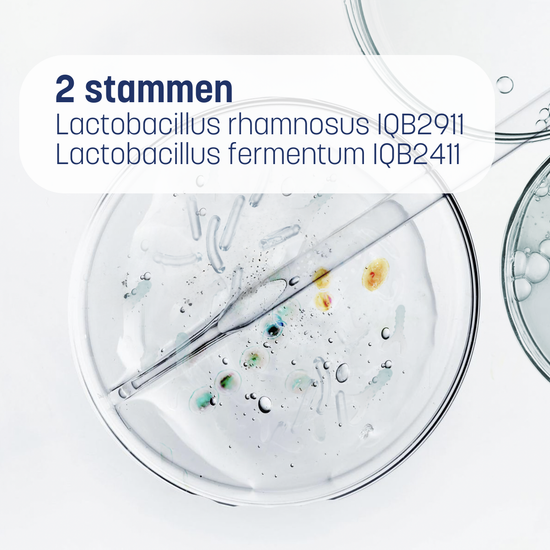

FEM NutriBiomix
Vrouwelijke energie begint in de darm.
complete dagelijkse vrouwensupplement
WAT ZIT ERIN EN WAAROM HET WERKT
WAAROM DARMGEZONDHEID BELANGRIJK IS
WELKE RESULTATEN KAN IK VERWACHTEN?
HOE TE GEBRUIKEN









-

Ontwikkeld door biologen
-

Belgisch bedrijf
-

Snelle en gratis levering
-

Veilige betaling
VOOR WIE?

Voor vrouwen die zich herkennen in één of meerdere van deze gevoelens

Weinig of wisselende energie, ondanks een gezonde levensstijl

Zware, ongemakkelijke of wisselende spijsvertering

Stemmingswisselingen, een gevoel van onevenwicht

Doffere huid, minder glow
Fem NutriBiomix is er voor vrouwen die hun totale welzijn willen ondersteunen, energie, spijsvertering, huid en balans, door te starten waar het telt: een optimale opname en benutting van voedingsstoffen.

Aanhoudende vermoeidheid, oncomfortabele spijsvertering, doffe huid, moeilijke cycli…
Deze signalen komen voor bij veel vrouwen. Ook met een goede levensbalans. Waarom? De oorzaken zijn divers. Maar er is er één die vaak over het hoofd wordt gezien: de opname van voedingsstoffen. Het gaat niet alleen om wat je eet, maar om wat je lichaam opneemt. De opname van voedingsstoffen hangt af van je darmmicrobiota. Als die uit balans is, worden zelfs de beste vitamines niet volledig benut.
Fem NutriBiomix ondersteunt je microbiota zodat je lichaam eindelijk profiteert van wat je het geeft: energie, spijsverteringscomfort, uitstraling.
Gevalideerd door de wetenschap van het microbioom
De cijfers spreken voor zich

“Na 2 weken voel ik me nu al beter: minder een opgeblazen gevoel, ik voel me lichter en ik krijg weer de controle terug! ”
— Sanne U.
Gegevens uit de wetenschappelijke literatuur. De effecten kunnen variëren per persoon.
Hoe Fem NutriBiomix anders werkt
-
 Erkende stammen
Erkende stammenGerichte microbiotische stammen
Fem NutriBiomix bevat twee microbiotische stammen die van nature aanwezig zijn in de darm:
- Lactobacillus rhamnosus IQB2911
- Lactobacillus fermentum IQB2411
Hun rol:
Bijdragen aan het darmevenwicht en een gunstige omgeving creëren voor de opname van vitamines en mineralen. -
 Gerichte opname
Gerichte opnameDosering in afwisseling
Je lichaam heeft geen meer ingrediënten nodig. Het moet ze beter opnemen.
Fem NutriBiomix verdeelt zijn voedingsstoffen over twee capsules die je afwisselend inneemt:- Dag 1 – Essentiële voedingsstoffen
Magnesium, IJzer, Vitamines C, A, D3, B6, B9, B12, Biotine - Dag 2 – Microbiota + Sporenelementen
Microbiotische stammen + Zink, Selenium, Calcium, Koper
Waarom? Om competitie tussen voedingsstoffen te vermijden en hun benutting door je lichaam te optimaliseren.
- Dag 1 – Essentiële voedingsstoffen

Door biologen, voor alle vrouwen
“De effectiviteit van voedingsstoffen hangt niet alleen af van wat je inneemt, maar vooral van wat je lichaam daadwerkelijk kan gebruiken. Daarom hebben wij het microbioom centraal geplaatst in Fem NutriBiomix.”
SOPHIE HABRYN AND KRISTINA CUEVA
Biologen en medeoprichters van BIODAMI
HOW FEM NutriBiomix HAS MADE THE DIFFERENCE

De microbiota-aanpak voor vrouwelijk welzijn
De meeste supplementen focussen op wat je inneemt.
Wij focussen op wat je lichaam opneemt.
Fem NutriBiomix werkt waar het begint: je darmmicrobiota — de basis van de opname van voedingsstoffen, energie, immuniteit en hormonaal evenwicht.
Klaar om het verschil te voelen?
Waarom 3 maanden?
Het microbioom heeft gemiddeld 6 tot 8 weken nodig om duurzaam in balans te komen en de opname van voedingsstoffen te optimaliseren.
1 maand

3 maanden

5 maanden

Aanbevelingen voor gebruik